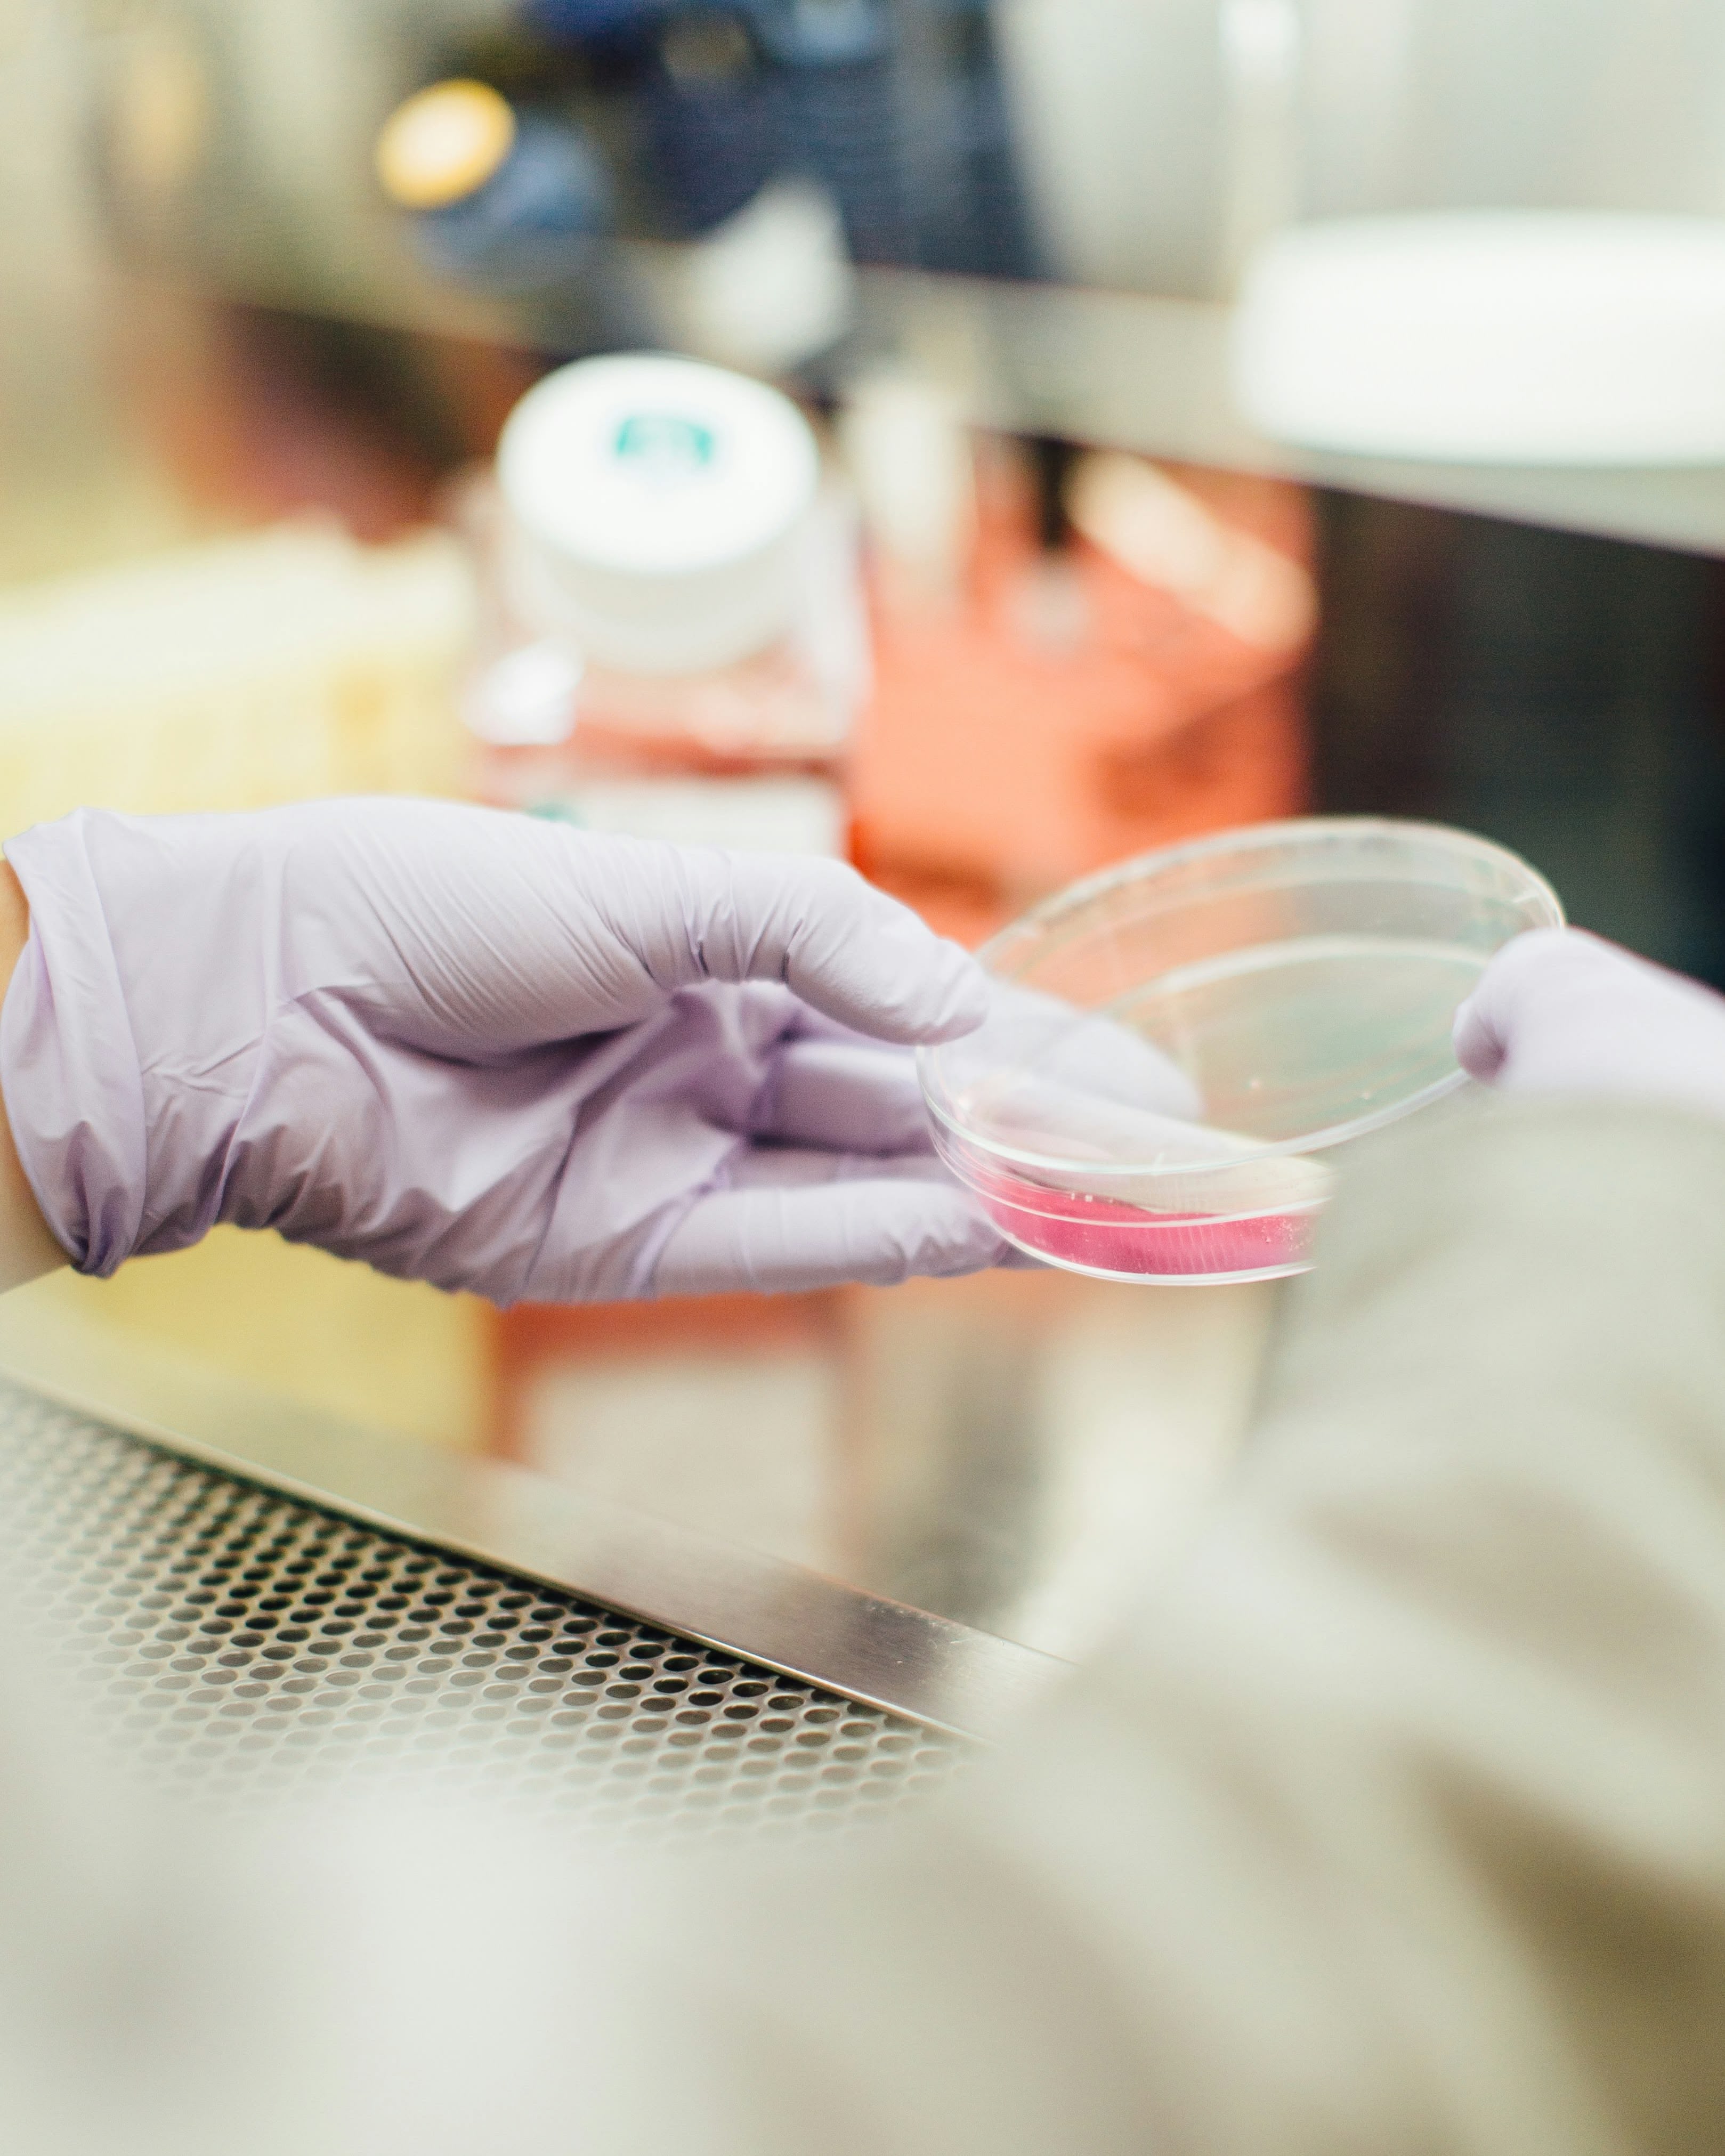

Born to Bring Luxury to the Road
Flava Car Scents was created with a simple yet powerful mission – to re-define the way you experience fragrance in your car. Inspired by the world’s most loved designer aftershaves and perfumes, we set out to bring luxury scents to every journey, making every drive feel as refined and captivating as stepping into your favourite boutique fragrance store.

High-Performance Car Scents That Tell a Story
What started as an idea between passionate entrepreneurs quickly grew into a brand that car lovers and fragrance enthusiasts trust. Our love for quality, style, and innovation has driven us to craft long-lasting, high-performance car scents that offer more than just a pleasant aroma – they create an experience.
Where Innovation Meets Fragrance
At Flava, we take pride in our expertly crafted scent formulations. Every fragrance goes through rigorous testing to ensure it captures the essence of high-end designer perfumes and aftershaves while being perfectly suited for your car. Whether you prefer a bold, masculine oud, a fresh citrus burst, or a delicate floral touch, we have a scent that speaks to your style.

Transform Your Car's Ambiance with Flava Fragrances
Our premium fragrances are available in a variety of formats, including:
• Sleek tins and cans for effortless fragrance
• Powerful turbo can sprays for a blast of freshness
• Speed air vent diffusers for a dynamic scent throw
• Elegant wood-infused designs for a natural and long-lasting aroma
With Flava, you’re not just freshening your car – you’re making a statement.
A Community Built on Scent & Style
Our customers aren’t just buyers; they’re part of the Flava movement – a collective of individuals who appreciate luxury, detail, and unforgettable experiences. From everyday commuters to car enthusiasts, we’re here to ensure that every journey feels as indulgent as the destination.
Flava Car Scents is more than just a fragrance brand – it’s a lifestyle. Join us on this scented journey and let every drive tell a story.












